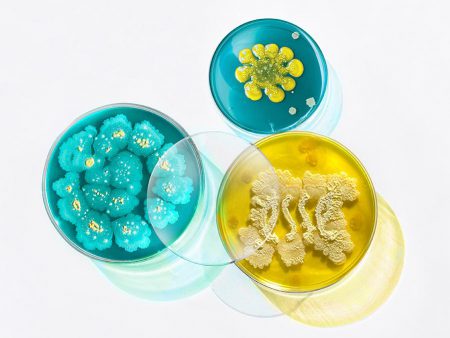

All the questions you need answered by Esse!
For the past two decades, we have been producing industry-leading skincare products with significant anti-ageing benefits. With more people choosing brands that believe in sustainability and show real results, we…